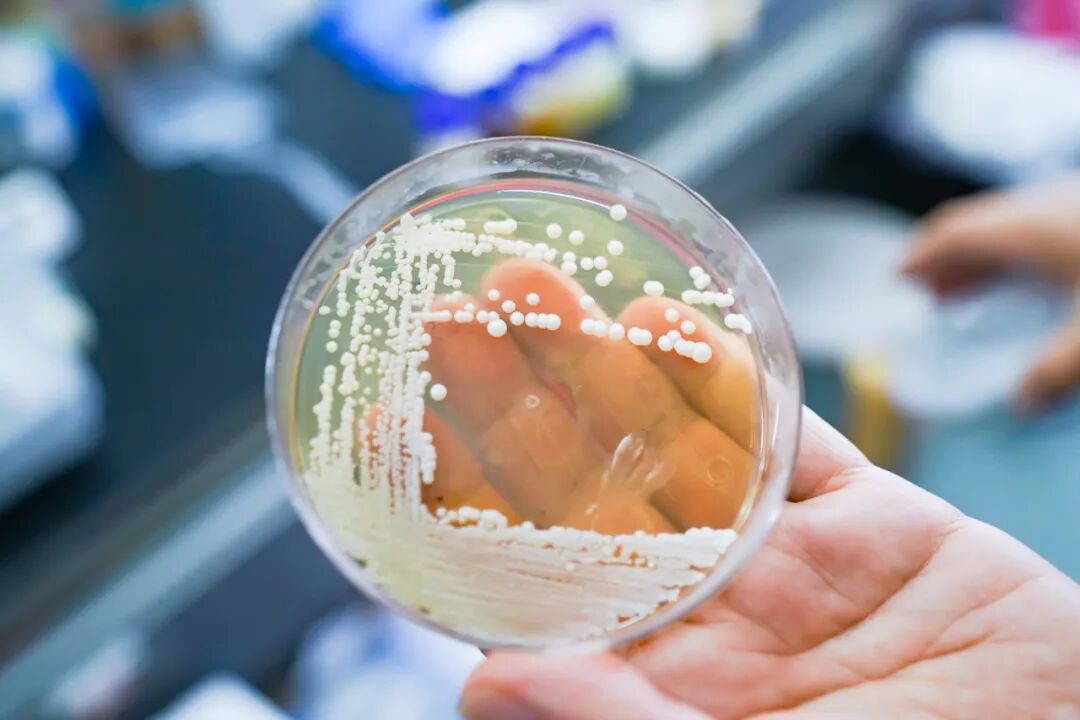

乡村要振兴,人才是关键。为高水平构建本市“百千万”乡村人才梯队,根据《上海市人才计划管理办法》,市农业农村委组织开展了东方英才计划乡村振兴领域人才选拔工作。自2023年项目启动以来,已累计选拔培养了多批立足乡土、奉献“三农”的杰出代表。
他们扎根在农业农村一线,是攻坚关键核心技术的科研先锋,是引领乡村产业发展的实干力量,是投身基层治理的智慧担当。他们用行动与才华,为上海探索城乡融合发展新路注入了强劲动能。
为集中展现他们的风采,发挥其示范引领作用,我们特开设本专栏,讲述他们深耕沃土、服务乡村的生动故事,分享他们的智慧与经验,弘扬新时代“新农人”的创新创业精神。期待通过他们的榜样力量,激励更多有志之士汇聚于此,共同为农业农村现代化事业贡献力量。
上海理工大学健康科学与工程学院教授 夏永军
发酵食品通常指利用微生物进行发酵加工产生的一类食品,其历史悠久、应用广泛,是现如今人们饮食中的重要组成部分。微生物,或者说微生物中的乳酸菌作为发酵过程中的“灵魂”,不仅决定了发酵制品生产的成败,还赋予了发酵制品独特的风味、质地与一定的益生特性。
上海理工大学夏永军教授具有20年食品微生物选育与发酵食品研发领域研究经验,曾先后担任中国食品科学技术学会益生菌分会理事,上海食品微生物工程技术研究中心副主任等职务。2013年加入上海理工大学以来,他主要从事食品微生物资源开发及应用工作,包括益生菌功能评价、功能物质基础解析,益生菌发酵剂在乳制品、果蔬制品、肉制品中的应用研究等。凭借在微生物选育与发酵食品领域的科研能力和技术贡献,2024年12月,夏永军入选东方英才计划拔尖项目。
建一座3000株的菌种“宝库”
乳酸菌是发酵活动的“芯片”。研究乳酸菌,首先要进行收集、筛选。夏永军介绍,为了获取最原始、最纯正的乳酸菌,团队成员经常长途跋涉,走遍云南、新疆、内蒙古等偏远地区,在当地农户、牧民家中搜集。“不同地区、不同环境会培养出不一样的菌株。我们让天南地北的学生从老家带来泡菜、酸奶、自家酿的酒等,这些比较原始,其中可能就有还未被发掘的菌种。”正是长年累月的坚持,团队建立的食品乳酸菌种资源库如今已涵盖20多个菌株、3000多株微生物,获得功能明确的自主知识产权核心菌种40余株,真正成了一座乳酸菌的“宝库”。
团队通过构建乳酸菌高效基因编辑系统,利用系统对乳酸菌的各项功能机制进行解析,逐渐加快了研究速度。“过去做功能评价,仅一个基因的功能验证可能需要花费一个月时间,现在却只需要七天,且可以同步做多个基因的功能验证,大大加快了科研速度。”
团队还在乳酸菌活性保持技术和高效递送技术、高活性制备与复配优化技术、产品应用开发等乳酸菌应用关键技术方面形成了重要的技术发明,整体技术已经产业化应用,取得良好的经济效益,打破了国外技术与产品的市场垄断。
“通过这些技术,我们有了自己的菌株,也有了制备乳酸菌发酵剂、菌粉等产品的设备。通过工业化生产,一系列具有特殊功效的冻干菌粉就能够真正地改善我们的生活。”
助力食品行业与乡村振兴的发酵“魔法”
传统自然发酵工艺可控性差、生产效率低、产品风味与品质不稳定,究其原因主要是发酵机制不明、优良乳酸菌发酵剂缺乏、工业化生产技术落后。而夏永军团队的一大研究成果,便是突破乳酸菌发酵剂高效筛选与制备技术瓶颈,创制系列发酵食品。

团队开发系列益生菌发酵剂产品,应用于乳制品、果蔬以及谷物等发酵食品产品开发,在河北一然生物、云南猫哆哩集团、上海金枫酒业、君乐宝乳业等企业应用,三年累计新增产值26.7亿元。
团队和金枫酒业合作,利用微生物科技降低酿酒过程中的酸败率,提高生产效率,这样一来黄酒的饮用舒适度也得到了提升。而在云南,团队利用当地特色林果资源酸角、滇橄榄等,与猫哆哩集团进行深度合作,通过益生菌赋能,开发了水果大师等系列产品,分别以果肉、果皮以及果渣等部位开发了多种产品。“以前只能用果肉,现在果核里面的纤维、果渣、果皮等经过微生物发酵,实现‘全果利用’,能够显著提高整体利用率。”夏永军介绍,“比如酸角口感酸涩,过去卖价在每斤一两块钱,现在能够卖到每斤六到八元,农户的收入显著增加了。”
目前,团队还在进行全谷物食品发酵方面的研究。“全谷物食品在加工和储存过程中面临着营养组分损失、风味口感不佳等问题。我们从全谷物预处理工艺以及酵母发酵工艺入手,开发酵母全谷物发酵食品,让全谷物不再难以下咽。”夏永军表示,比如糙米用微生物发酵的方式软化其纤维素,保留其营养成分的同时,破坏其内部结构,让糙米的口感更好,其中的营养也更易被人体吸收……团队建立了谷物食品质构稳定、营养提升及风味增强的低温长时发酵技术,整体技术已经产业化应用,取得良好的经济效益,打破了国外技术与产品的市场垄断。
发酵剂成果打破进口依赖
“乳酸菌包含两类应用,一种是益生菌、另一种则是发酵剂。这是国内过去较为薄弱的领域。”夏永军表示。过去,国内绝大部分的酸奶、泡菜直投式发酵剂依赖进口。而夏永军团队率先建立乳酸菌菌种大规模筛选与定向进化平台,获得多株性能优良的乳酸菌发酵剂菌株,并利用CRISPR等技术解析风味、质构、营养提升机制;构建基因组规模代谢网络模型,实现了对多菌种的科学复配,开发22种国产发酵剂,售价仅为国外产品的50%。

在研究中,团队逐步建立了乳酸菌高密度发酵技术,首次发现乳酸菌冻干存活率控制靶点,并以此为基础发明了乳酸菌冻干预处理关键技术、乳酸菌冻干关键点控制技术,创制了乳酸菌高效制备系统装备,实现了乳酸菌发酵剂高活力制备,在乳酸菌制备关键技术及制备装备的创制方面形成了重要技术发明。“高活性乳酸菌发酵剂创制关键技术及应用”这一成果还于2020年获得上海市技术发明奖一等奖。
在夏永军看来,发酵不是神秘的“老法子”,而是可以被精确设计的未来食品芯片。从云南红土高原的酸角到塞外草原燕麦,从实验室里的基因编辑平台到食品企业的生产线,他的研究,就是要让“看不见”的微生物,做成老百姓吃得到的大健康产品,也让“发酵”成为农业产业现代化发展的新引擎。
文字:陈祈
图片:杜洋域
编辑:黄倩欣